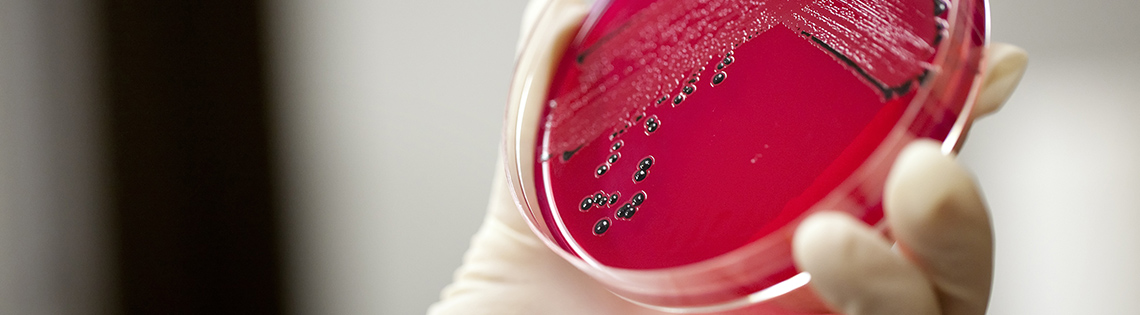

Advising
The deadlines and application process for applying to the LSU Health Sciences (LSUHSC) School of Allied Health vary from program to program. Check the website for each program for application deadlines and information.
The application dates vary from department to department and in some cases students can apply several times during the academic year. Make certain you follow the guidelines and instructions for submitting applications. A list of approved LSU equivalent pre-requisites are available with Anthony Oster, The Allied Health Adviser, in room 150 Himes Hall.
- LSU students with questions about pursuing an Allied Health degree may schedule an appointment with Anthony Oster using the Navigate Student App found in the Apple Store or Google Play Store.
You can make a virtual appointment with Anthony Oster by using the Navigate app on your phone:
- Select the "Appointments" widget
- Select “Academic Advising (UCFY & UCAC)” for the care unit
- Select “Allied Health Advising" as your reason for the appointment. Note in the "Comments" box what you are needing assistance with and include your phone number and intended major/concentration
- Lastly, select the day, time, and advisor. The app will send you a confirmation email/text to let you know the appointment has been created. The advisor you scheduled your appointment with will email you prior to the appointment time in order to invite you to join a Zoom video/audio appointment and to send you important documents. You can communicate with your advisor via email if you have any questions or concerns about the Zoom appointment.
- Prospective or incoming students currently without an LSU class schedule may email aoster@lsu.edu to schedule an appointment.
Bachelor's Degree Programs
Students wishing to pursue careers in nursing, medical technology, respiratory therapy, dental hygiene, or dental laboratory technology may follow a non-degree granting, prerequisite program to prepare students to apply for study in degree-granting programs offered at the New Orleans or Shreveport campuses. Students typically spend the first two to three years of their undergraduate careers at LSU’s main campus before making the required transfer to LSUHSC or other medical schools.
The first 37-45 hours of each of these programs are completed in the University Center for the Freshman Year and the remaining prerequisite courses are completed in the University Center for Advising & Counseling. Students finish the final two to three years of degree requirements at the LSUHSC or other medical schools, contingent upon acceptance into their programs.
Graduate Study Programs
Degrees such as nurse practitioner, nurse anesthetist physical therapy, occupational therapy, physician assistant and rehabilitation counseling are offered at the graduate level. Students are required to complete an undergraduate degree in addition to specific course pre-requisites, obtaining a minimum amount of direct patient contact and earning a minimum score on the Graduate Record Examination (GRE). The specific details for enrollment will vary on based on which program a student is interested in applying to, though most programs within these areas of study typically operate on a competitive admissions protocol.
After obtaining a bachelor’s degree and satisfying the required pre-requisite work students will complete their course of study at the LSUHSC or other medical schools, contingent upon acceptance into their programs. A full listing of these programs is available below.
Other Healthcare Related Degrees
Students who are interested in other programs that do not fall under the categories listed below such as pharmacy, optometry, radiologist technology, etc., are urged to contact the professional program that they wish to attend for a list of their prerequisites since LSU and LSU Health Sciences Center do not offer these programs. It may be possible to take prerequisites for other colleges and universities at LSU but the authority to grant such a request is the domain of the outside college or university.
Pre-Professional Major Information
Click on the following pre-professional major for more information:
LSUHC-New Orleans
Dental Hygiene (Bachelors)
Dental Laboratory Technician (Bachelors)
Cardiopulmonary Science (Bachelors)
Medical Laboratory Science(Bachelors)
Occupational Therapy (Masters)
Physician Assistant (Masters)
Counseling (Masters)
Speech-Language Pathology (Masters)
Audiology (Doctorate)
Physical Therapy (Doctorate)
LSUHSC-Shreveport
Cardiopulmonary Science (Bachelors)
Medical Laboratory Science (Bachelors)
Physician Assistant (Masters)
Occupational Therapy (Doctorate)
Speech-Language Pathology (Masters)
Physical Therapy (Doctorate)